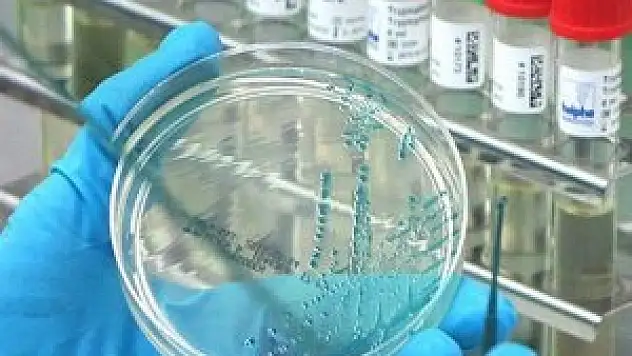
H10N8 kuş gribi virüsü insana bulaştı

Sağlık
Güncel sağlık haberi

Türk Kızılayı 11 ülkede yüzleri güldürdü

Kanser bir yılda 8 milyon can aldı

Sare Davutoğlu, Konya'da

Sivas'ta kuş gribi iddiası

Yeni yılda yeni siz

Doğanın şifacıları bakanlık takibinde

ANMEG Yönetim Kurulu Başkanı Ahmet Özer'in Acı Günü

Melis yarın yeniden "doğacak"

Diz ağrıları kalıcı hasarlara yol açabiliyor

Propolisin faydaları bilimsel olarak kanıtlandı
H10N8 kuş gribi virüsü insana bulaştı

Sahte ilaç üreten, satan ve sattırana "hapis"

Mevlevi Mutfağı geleneği Konya'da yaşatılıyor

Kış lastiği artık otomobillerde de zorunlu

Balıkçı anne ile oğlunun buzda ekmek mücadelesi

Migrende ağrı kesiciye sarılmak bağımlılık yapıyor

20 yaş dişi diğer dişlerden farklı mıdır?

Kar körlüğüne karşı güneş gözlüğü kullanın

Konya Şeker Bir Üründe Daha İthalat Devrini Kapattı

"Kimse rahatsız olmasın" diye dışarıya bile çıkamıyor

Sadece ısınmak istiyorlar

'Fatma' ve 'Mehmet'ten vazgeçilmedi

Türkiye sağlıkta önemli bir merkez

İlmek ilmek büyüyen Suriye kampanyası

İkinci DNA kodu bulundu

Sahte ilaç operasyonunda tutuklama

Sağlıkta '31 Aralık' korkusu!

Yıldızlar Lösemili Çocukları Ağırladı

Başbakan talimat verdi dünyada bir ilk olacak

SMMM odasında kan bağışı kampanyası

Halep Cezaevi'nde 10 mahkum donarak öldü

Müezzinoğlu'ndan sağlıklı yaşam reçetesi

"İlaçları eczaneden alın"

Emine "11.12.2013 14:15" bebeği

Müziğin inanılmaz etkisi

İlaçta yeni sistem

Türk Kızılayı'ndan kan bağışı kampanyası

Dondurucu soğuğa rağmen avlanıyorlar

Japonya'da Türk moda rüzgarı

Milli Gençlik Vakfı Yeniden mi Açılıyor?











